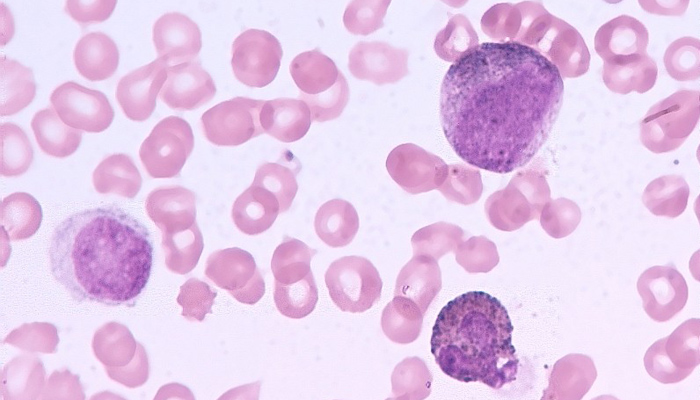
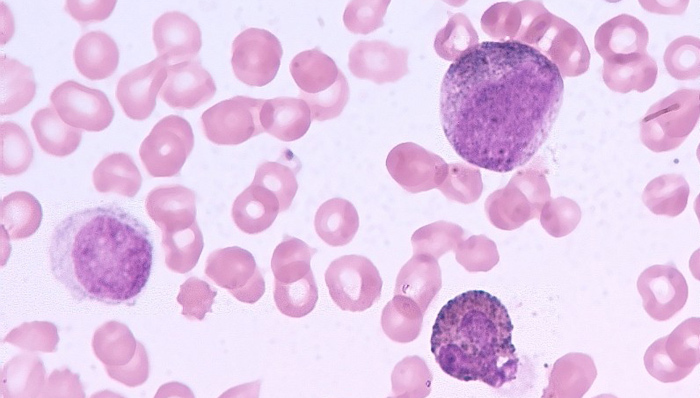
癌症,白血病

据BBC当地时间16日报道,美国研究人员通过基因改造白细胞的方法治疗白血病患者,结果发现有90%的晚期病人出现好转。
来自西雅图贺勤森癌症研究中心(Fred Hutchinson Cancer Research Center)的医学专家在美国科技进步协会的华盛顿年会上公布了这一发现。
根据所公布的实验,研究人员先将白血病人体内的T淋巴细胞取出,T淋巴细胞能够帮助消灭受感染的组织。
此后研究人员对T淋巴细胞进行了基因定向改造,用嵌合抗原受体修饰T细胞,让其能识别并杀灭肿瘤细胞。
研究中心的里德尔教授(Stanley Riddell)称在使用了这种新疗法之后,有90%的急性淋巴细胞白血病患者出现了好转,体内没有发现任何白血病细胞了。
但是有7位病人出现了不良反应正在接受重症监护,还有2名病人死亡。
实验的相关数据还没有正式发布,也尚未经过同行审查,医学专家们认为这项实验的结果很“振奋人心”,但只是在治疗癌症上的“一小步”。
有专家指出这种针对白血病的疗法会比传统疗法例如化疗,带来的副作用更大。
来自英国癌症研究中心的沃斯利博士(Alan Worsley)称,已经有医生将这种疗法用于临床试验了,这种基因改造法针对白血病人的效果比较明显。
但是沃斯利指出,这种方法用在实体肿瘤比如乳腺癌时,效果就没有那么好了,因此现在的问题是“如何让这种疗法用于其他类型的癌症”。
- - - - - - - - - - - - - - - - - - - - - - - - - - - - - - - - - - - - -
更多天下事,请戳天下首页(tianxia.jiemian.com)。动动手指,长按二维码,关注【最天下】微信公众号:theveryworld (如果长按不行,就麻烦看官扫下呗)

评论